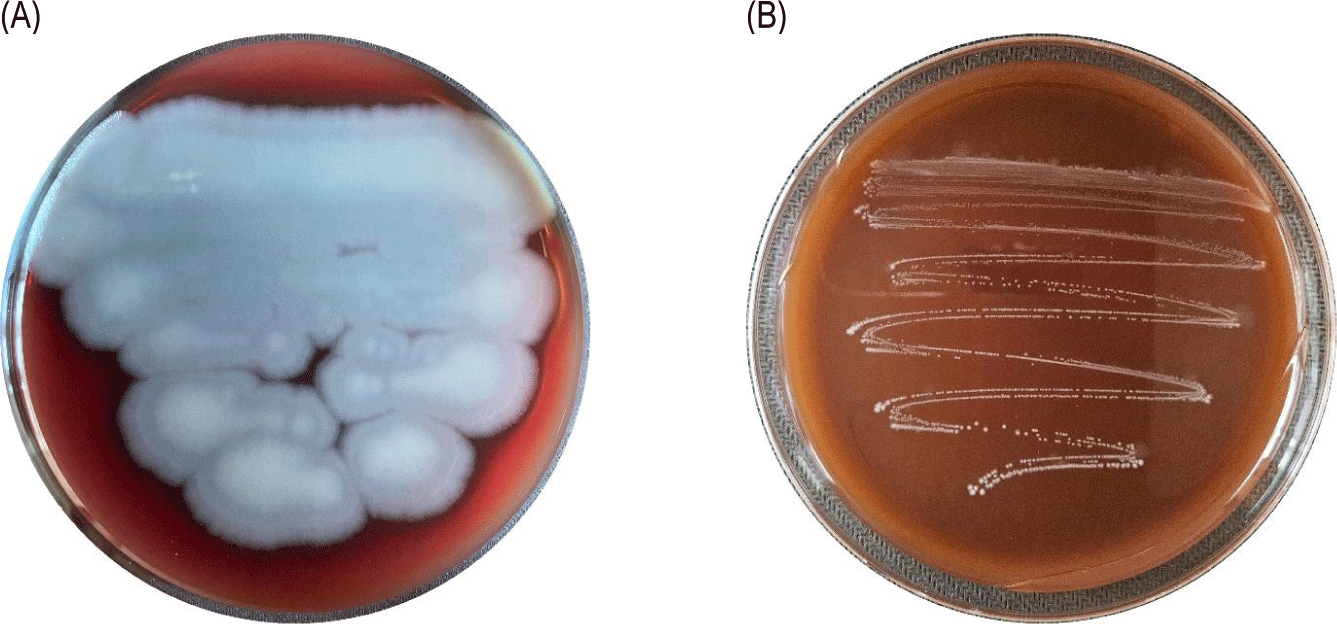
jmsb-43-4-277-g2
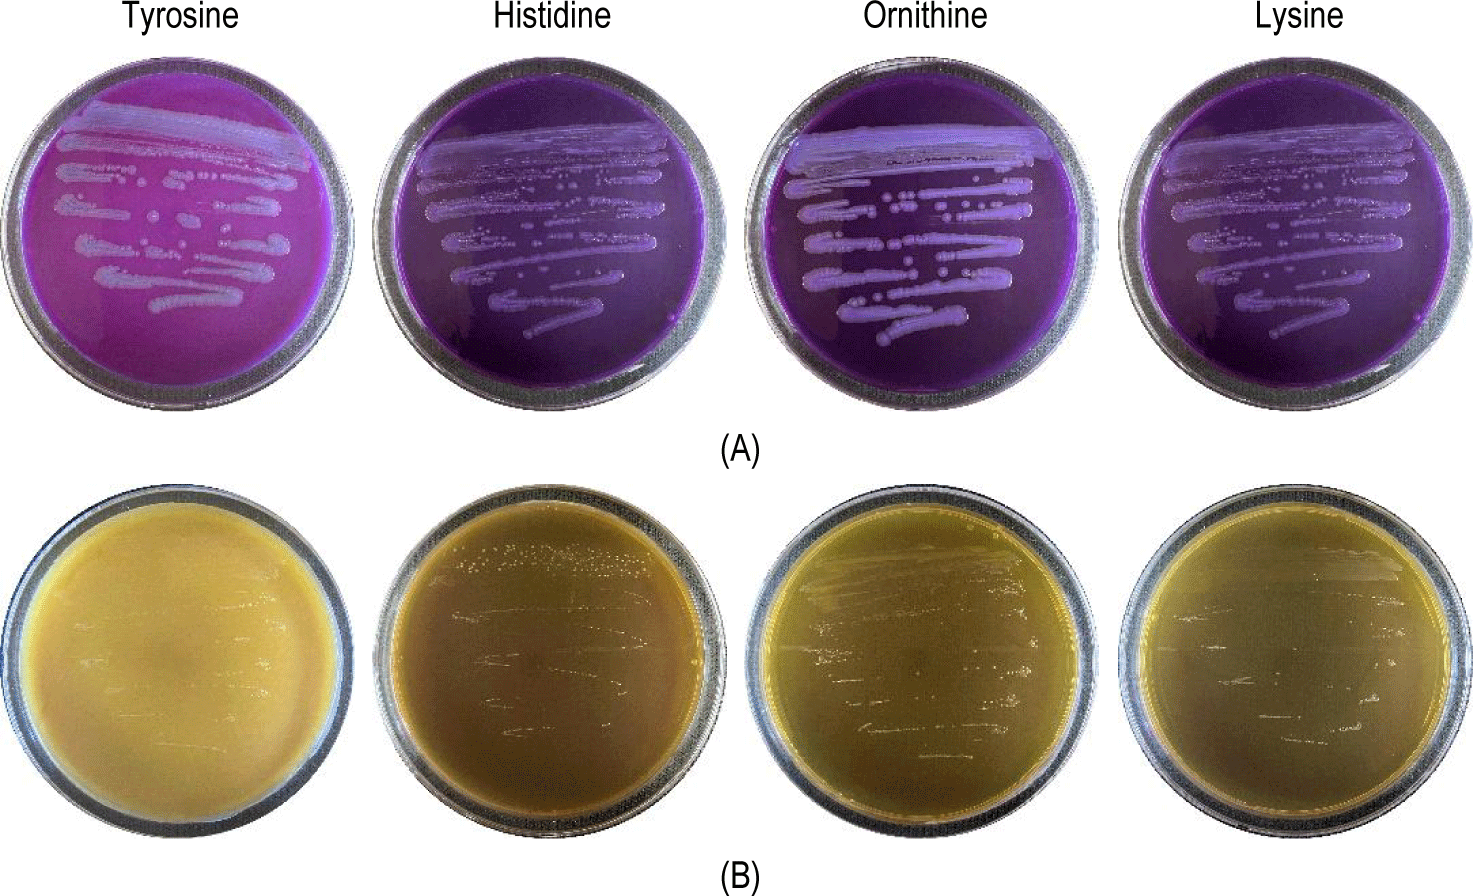
jmsb-43-4-277-g3

ARTICLE
김치 유래 Lactiplantibacillus plantarum CB5-30-3의 식물성 배지 발효 최적화 평가
이수원1
,
김재수1,*
Fermentation Optimization of Plant-Based Culture for Kimchi-Origin Lactiplantibacillus plantarum CB5-30-3
Suwon Lee1
,
Jaisoo Kim1,*
Author Information & Copyright ▼
1Department of Life Science, Graduate School, Kyonggi University, Suwon, Korea
*Corresponding author : Jaisoo Kim, Department of Life Science, Graduate School, Kyonggi University, Suwon, Korea, Tel : +82-31-249-9648, Fax : +82-31-249-9604, E-mail :
jkimtamu@kgu.ac.kr
© Copyright 2025, Korean Society of Dairy Science and Biotechnology. This is an Open Access article distributed under the terms of the Creative Commons Attribution Non-Commercial License (http://creativecommons.org/licenses/by-nc/3.0/) which permits unrestricted non-commercial use, distribution, and reproduction in any medium, provided the original work is properly cited.
Received: Sep 11, 2025; Revised: Dec 23, 2025; Accepted: Dec 24, 2025
Published Online: Dec 31, 2025
Abstract
This study aimed to isolate a safe, plant-based, culture-compatible probiotic strain from kimchi and optimize its cultivation conditions. A total of 100 lactic acid bacteria (LAB) were isolated and safety assessments (hemolytic activity, gelatinase, biogenic amine production, and antibiotic susceptibility) were conducted. Strain CB5-30-3, identified as Lactiplantibacillus plantarum using 16S rRNA sequencing and API 50 CHL analysis, showed no safety concerns. Among the eight plant-derived nitrogen sources and four sugars tested, the combination of soy peptone (A2SC), yeast extract (545 MG), and glucose resulted in the highest cell growth. The optimal carbon-to-nitrogen ratio was 1:1.5. Fermentation conditions were further optimized in a 5-L jar fermenter, revealing that 30℃, pH 6.0, and 100 rpm agitation provided the best growth performance, with efficient carbon utilization and reduced lactic acid accumulation. These findings suggest that L. plantarum CB5-30-3 can be effectively cultivated in animal-free media, highlighting its potential for sustainable probiotic production.
Keywords: Lactiplantibacillus plantarum; kimchi; plant-based medium; probiotics; fermentation optimization
서 론
프로바이오틱스는 적절한 양으로 섭취했을 때 숙주의 건강에 유익한 효과를 제공하는 살아있는 미생물로 정의되며, 식품, 의약품, 건강기능식품 등 다양한 산업 분야에서 활발하게 활용되고 있다[1,2]. 이 중 유산균은 GRAS(generally recognized as safe)로 분류되어 있으며, 장내 환경 개선, 항균 활성, 면역 조절 등 다양한 생리활성을 통해 대표적인 프로바이오틱스로 널리 평가받고 있다[3]. 최근에는 비건 및 채식 인구의 증가와 더불어 동물복지 및 윤리적 소비에 대한 사회적 관심이 확대되면서, 동물성 원료를 배제한 프로바이오틱 제품에 대한 수요가 증가하고 있다. 이에 따라 식물성 원료를 기반으로 한 프로바이오틱스의 배양 및 기능성 확보를 위한 다양한 연구가 진행되고 있으며, 특히 식물성 질소원과 탄소원을 활용한 배지 조성의 최적화가 중요한 과제로 부각되고 있다[4-6]. 김치는 대표적인 발효 채소식품으로 다양한 유산균이 자연적으로 발효 과정에 관여하며, 그 주성분이 식물성 재료로 구성되어 있다는 점에서 비동물성 기반의 프로바이오틱 균주를 분리하고 평가하기에 이상적인 소재로 간주된다[7]. 특히 김치 유래 유산균은 우수한 생존력과 장내 정착성, 기능성 발현 가능성 등으로 인해 프로바이오틱 개발을 위한 유망한 자원으로 주목받고 있다. 그러나 신규 균주의 상업적 적용을 위해서는 용혈성 여부, 항생제 내성, 바이오제닉 아민 생성 가능성 등과 같은 안전성 검토가 필수적이며, 동시에 식물성 배지에서의 성장 적합성 및 발효 공정 변수(온도, pH, 교반 속도 등)에 대한 최적화 연구가 선행되어야 한다[8].
본 연구에서는 김치 유래 유산균 가운데 안전성 평가를 통과한 Lactiplantibacillus plantarum CB5-30-3 균주를 선별하고, 식물성 펩톤과 이스트 추출물을 기반으로 한 배지에서 생육 특성을 분석하였다. 아울러 bottle scale 및 5 L jar fermenter 규모의 발효 실험을 통해 주요 공정 변수(온도, pH, 교반 속도)에 따른 균주 활성을 비교 평가함으로써, 동물성 성분을 배제한 지속 가능하고 경제적인 프로바이오틱 생산 공정의 가능성을 제시하고자 하였다.
재료 및 방법
1. 균주 분리 및 스크리닝
김치 시료 10종(배추김치 9, 무김치 1)을 PBS로 희석 후 stomacher로 균질화하고, MRS agar에 도말하여 30℃ 및 37℃에서 48시간 배양하였다. 유백색 콜로니를 선별하여 계대배양 후 20% glycerol에 보관하였다. 또한, L. plantarum CB5-30-3 균주는 한국미생물보존센터에 기탁하였으며, 기탁번호는 KCCM 90667이다.
2. 용혈성 실험
분리 균주를 blood agar에 획선 도말 후, 37℃에서 24시간 배양하여 용혈 여부를 확인하였다. 양성 대조군은 Bacillus cereus KCTC 1012를 사용하였다.
3. 젤라틴 분해능 평가
젤라틴 분해능 평가는 ASM Science의 권장 프로토콜에 따라 수행하였다[9]. 젤라틴 배지에 균주를 접종 후 30℃에서 5일간 배양하며 분해 여부를 관찰하였고, 4℃에서 냉각하여 효소에 의한 액화 여부를 확인하였다.
4. 바이오제닉 아민 생성능 평가
균주의 생체활성 아민 생성능 평가는 Bover-Cid 및 Holzapfel의 방법을 참고하여 수행하였다[10]. 히스타민, 카다베린, 티라민, 푸트레신 전구체가 포함된 배지에 접종 후 30℃에서 4일간 배양하였으며, 배지 색 변화로 아민 생성 여부를 판별하였다.
5. 항생제 감수성 평가
7종 항생제에 대해 E-test strip을 활용하였고, MRS agar에 도말 후 37℃에서 24–48시간 배양하여 MIC(minimum inhibitory concentration) 값을 확인하였다.
6. 16S rRNA 염기서열 분석
최종 선별 균주의 16S rRNA 유전자를 증폭하고 염기서열을 분석하여 GenBank와 비교, MEGA 11 프로그램으로 계통수 분석을 수행하였다. Neighbor-joining 방법을 통해 계통수(phylogenetic tree)를 구축하였다[11-13].
7. API 50 CHL Kit 동정
탄수화물 이용 특성을 확인하기 위해 API 50 CHL kit를 이용하였으며, 37℃에서 48시간 배양 후 데이터베이스를 통해 종 동정을 실시하였다.
8. 기초 생육곡선 분석
MRS broth에 접종하여 37℃, 100 rpm 조건에서 10시간 배양하며 2시간 간격으로 흡광도와 생균수를 측정하여 생육곡선을 도출하였다.
9. 식물성 질소원 선별
동물성 성분을 제거한 MRS 기초배지에 4종의 펩톤 및 4종의 이스트 추출물을 각각 단독 첨가하고, 37℃에서 10시간 배양하여 흡광도와 생균수를 측정하여 생육 성능을 비교하였다. 4종의 펩톤은 E210(Tatua, New zealand, potato-derived) Tatua 5260(pea-derived), HSP349(soy-derived), A2SC(Organotechnie, France, soy-derived)를 사용하였고, 4종의 이스트 추출물은 545MG(NuCel, France), 584MG(NuCel), 751MG(NuCel), 816PW(NuCel)를 사용하였다.
10. 식물성 탄소원 선별
선정된 식물성 질소원을 고정한 상태에서 glucose(Samyangcor, Korea), fructose(CJ, Korea), maltose(Hayashibara, Japan), sucrose(Samyangcor) 4종의 탄수화물을 단일 탄소원으로 적용하여 생육 특성을 평가하였다.
11. 발효 조건 최적화 실험
선별된 식물성 질소원, 탄소원 및 C:N 비를 바탕으로, 5 L jar fermenter를 이용하여 발효 조건 최적화 실험을 수행하였다. 기본 배양 조건은 37℃, pH 6.0, 100 rpm으로 설정하였으며, 이후 온도(30℃, 37℃, 40℃), pH(5.5, 6.0, 6.5), 교반 속도(50, 100, 150 rpm)를 각각 변화시켜 균주의 생육 특성에 미치는 영향을 평가하였다. 배양 중 일정 간격으로 시료를 채취하여 흡광도, 생균수, pH, 젖산 농도, NaOH 사용량 등을 측정하였다.
결과 및 고찰
1. 분리 균주의 선별 및 동정
김치로부터 총 100주의 유산균을 분리하고 일련의 안전성 평가를 실시한 결과, 최종적으로 CB5-30-3 균주가 선별되었다. 해당 균주의 16S rRNA 유전자 염기서열 분석을 통해 NCBI BLAST에서 비교한 결과, L. plantarum과 99.9% 이상의 상동성을 나타내어 본 종으로 동정되었다(Fig. 1). 이와 같은 결과는 김치가 식물성 유산균의 유용한 자원이 될 수 있음을 시사하며, Jung et al. 역시 김치 유래 유산균이 장내 정착성 및 기능성 발현 가능성 측면에서 우수하다고 평가하였다[14].
2. 생화학적 특성
API 50 CHL kit를 활용한 생화학적 분석에서 CB5-30-3은 총 25종의 탄수화물에 대해 양성 반응을 나타냈으며, API Web 동정 결과에서도 99.9% 이상의 유사도로 L. plantarum으로 확인되었다(Table 1). 이는 해당 균주가 다양한 식물성 탄수화물을 대사할 수 있는 잠재력이 있음을 의미하며, 식물성 배지 환경에서도 효과적인 생장을 기대할 수 있다.
Table 1.
Biochemical characteristics of the isolated strain using the API 50 CHL kit
| No. |
Characteristics |
Strain |
No. |
Characteristics |
Strain |
| CB5-30-3 |
CB5-30-3 |
| 1 |
Glycerol |
– |
26 |
Salicin |
+ |
| 2 |
Erythritol |
– |
27 |
D-cellobiose |
+ |
| 3 |
D-arabinose |
– |
28 |
D-maltose |
+ |
| 4 |
L-arabinose |
– |
29 |
D-lactose |
+ |
| 5 |
D-ribose |
+ |
30 |
D-melibiose |
+ |
| 6 |
D-xylose |
– |
31 |
D-saccharose |
+ |
| 7 |
L-xylose |
– |
32 |
D-trehalose |
+ |
| 8 |
D-adonitol |
– |
33 |
Inulin |
– |
| 9 |
Methyl-β D-xylopyranoside |
– |
34 |
D-melezitose |
+ |
| 10 |
D-galactose |
+ |
35 |
D-raffinose |
+ |
| 11 |
D-glucose |
+ |
36 |
Amidon |
– |
| 12 |
D-fructose |
+ |
37 |
Glycogen |
– |
| 13 |
D-mannose |
+ |
38 |
Xylitol |
– |
| 14 |
L-sorbose |
– |
39 |
Gentiobiose |
+ |
| 15 |
L-rhamnose |
+ |
40 |
D-turanose |
+ |
| 16 |
Dulcitol |
– |
41 |
D-xylose |
– |
| 17 |
Inositol |
– |
42 |
D-tagatose |
– |
| 18 |
D-mannitol |
+ |
43 |
D-fucose |
– |
| 19 |
D-sorbitol |
+ |
44 |
L-fucose |
– |
| 20 |
Methyl-α D-mannopyranoside |
+ |
45 |
D-arabitol |
– |
| 21 |
Methyl-α D-glucopyranoside |
– |
46 |
L-arabitol |
– |
| 22 |
N-acetylglucosamine |
+ |
47 |
Potassium gluconate |
+ |
| 23 |
Amygdalin |
+ |
48 |
Potassium 2-ketogluconate |
– |
| 24 |
Arbutin |
+ |
49 |
Potassium 5-ketogluconate |
– |
| 25 |
Esculin |
+ |
|
|
|
Download Excel Table
3. 안전성 평가(용혈성, 젤라틴화, 바이오제닉 아민, 항생제 감수성)
CB5-30-3 균주는 용혈 반응, 젤라틴 가수분해, 바이오제닉 아민 생성 시험에서 모두 음성 결과를 보였으며, 이는 비병원성 및 인체에 무해한 프로바이오틱 특성을 지님을 의미한다(Figs. 2 and 3). 또한, 7종 항생제에 대한 감수성 시험 결과 모든 항목에서 EFSA에서 제시한 microbiological cut-off 이하의 MIC 값을 나타내었다. EFSA 기준에 따르면 일부 유산균에서 관찰되는 내재적(intrinsic) 내성은 유전적 전이 가능성이 없어 안전성 문제로 간주되지 않으며, cut-off 이하의 MIC 값은 획득(acquired) 내성의 부재를 의미한다. 따라서 본 균주는 항생제 내성 유전자의 보유 가능성이 낮아 안전한 균주로 평가될 수 있다[8] (Table 2). 이는 신규 균주의 상업적 활용을 위한 필수 조건을 충족하는 결과이다.
Fig. 2.
Hemolytic activity of the positive control and the isolated strain on blood agar plates. (A) Positive control (Bacillus cereus KCTC1012), (B) Lactiplantibacillus plantarum CB5-30-3.
Download Original Figure
Fig. 3.
Results of biogenic amine production test for the positive control and the isolated strain. (A) Positive control (Bacillus cereus KCTC1012), (B) Lactiplantibacillus plantarum CB5-30-3.
Download Original Figure
Table 2.
Antibiotic susceptibility test results of the isolated strain
| Minimum inhibitory concentration (MIC) μg mL–1 of antibiotics to Lactiplantibacillus plantarum strains |
| Strains |
Am |
Ch |
Cm |
Em |
Gm |
Km |
Te |
| CB5-30-3 |
0.19 |
3 |
2 |
0.5 |
6 |
64 |
6 |
| EFSA |
2 |
8 |
4 |
1 |
16 |
64 |
32 |
Download Excel Table
4. 기초 생육곡선 분석
CB5-30-3의 생육곡선 분석 결과, 6시간 시점에서 로그 생장기의 중간 지점에 해당함을 확인하였으며, 해당 시점을 기준으로WCB(Working Cell Bank)를 제작하였다(Fig. 4). 이 시점은 후속 실험에 활용될 기준 배양시간으로 설정되어 균주의 활성이 최대치에 도달하는 시기로 활용되었다.
Fig. 4.
Results of basic growth curve analysis. Bacterial growth was monitored by measuring optical density at 600 nm (OD600, dashed line) and viable cell counts (CFU/mL, solid line) over time. Data are presented as mean±SD from three independent experiments (n=3).
Download Original Figure
5. 식물성 질소원 선별
총 8종의 식물성 질소원을 대상으로 생육 활성을 평가한 결과, 펩톤 계열의 A2SC와 이스트 추출물 계열의 545MG가 가장 우수한 생육을 나타내어 이후 실험에 사용되었다(Fig. 5). 본 결과는 D’Almeida et al.의 연구와도 일치하며, 이들은 식물성 원료 기반 배지에서 프로바이오틱 균주의 성장 가능성을 제시한 바 있다[15]. 이는 동물성 성분을 대체할 수 있는 식물성 소재의 실용성을 뒷받침한다.
Fig. 5.
Effects of different plant-based nitrogen sources on optical density and viable cell counts of Lactiplantibacillus plantarum CB5-30-3. (A) Optical density at 600 nm (OD600) changes with different plant-based peptone sources. (B) Colony-forming units per milliliter (CFU/mL) under different plant-based peptone sources. (C) Optical density (OD600) changes with different plant-based yeast extract sources. (D) Colony-forming units per milliliter (CFU/mL) under different plant-based yeast extract sources. Data are presented as mean±SD from three independent experiments (n=3).
Download Original Figure
6. 식물성 탄소원 및 C:N 비율 선별
탄소원 선별 실험에서 glucose가 가장 높은 생육 활성을 보였고, 탄소와 질소원의 최적 혼합 비율은 1:1.5로 확인되었다(Fig. 6). 이러한 결과는 해당 균주가 glucose 대사에 효과적이며, 질소 공급량을 다소 높게 유지할 때 대사 활성이 극대화됨을 시사한다. 특히, Žvirdauskienė et al.은 유산균 배양 시 질소원 비율이 생균수에 결정적 영향을 준다고 보고하였다[5].
Fig. 6.
Effects of carbon sources and carbon-to-nitrogen (C:N) ratio on the growth of Lactiplantibacillus plantarum CB5-30-3. (A) Optical density (OD600) profiles with different carbon sources. (B) Colony-forming units per milliliter (CFU/mL) under different carbon sources. (C) Optical density (OD600) profiles under varying carbon-to-nitrogen ratios. (D) Colony-forming units per milliliter (CFU/mL) under varying carbon-to-nitrogen ratios. Data are presented as mean±SD from three independent experiments (n=3).
Download Original Figure
7. 발효 조건 최적화(온도, pH, 교반 속도)
5 L jar fermenter를 활용한 발효 실험에서 30℃, pH 6.0, 교반속도 100 rpm 조건에서 가장 우수한 생육 활성을 나타냈다(Tables 3–5, Figs. 7–9).
Table 3.
Summary of carbon source consumption, alkali consumption, and lactate accumulation during fermentation at different temperatures
| Temperature (℃) |
C0 (g/L) |
Cend (g/L) |
Total carbon consumption (g/L) |
Alk0 (mL) |
Alkend (mL) |
Total alkali consumption (mL) |
Lac0 (g/L) |
Lacend (g/L) |
Total lactate accumulation (g/L) |
| 37 (control) |
60.00 |
0.00 |
60.00 |
1,200 |
20 |
1,180 |
0.00 |
18.08 |
60.00 |
| 30 |
10.60 |
49.40 |
440 |
760 |
10.36 |
60.00 |
| 40 |
14.60 |
45.40 |
470 |
730 |
13.70 |
57.14 |
Download Excel Table
Table 4.
Summary of carbon source consumption, alkali consumption, and lactate accumulation during fermentation at different pH
| pH (condition) |
C0 (g/L) |
Cend (g/L) |
Total carbon consumption (g/L) |
Alk0 (mL) |
Alkend (mL) |
Total alkali consumption (mL) |
Lac0 (g/L) |
Lacend (g/L) |
Total lactate accumulation (g/L) |
| 6.0 (control) |
60.00 |
4.28 |
55.72 |
1,200 |
200 |
1,000 |
0.00 |
14.36 |
14.36 |
| 5.5 |
11.92 |
48.08 |
500 |
700 |
10.24 |
10.24 |
| 6.5 |
0.56 |
59.44 |
100 |
1,100 |
13.56 |
13.56 |
Download Excel Table
Table 5.
Summary of carbon source consumption, alkali consumption, and lactate accumulation during fermentation at different agitation speed
| Agitation speed (rpm) |
C0 (g/L) |
Cend (g/L) |
Total carbon consumption (g/L) |
Alk0 (mL) |
Alkend (mL) |
Total alkali consumption (mL) |
Lac0 (g/L) |
Lacend (g/L) |
Total lactate accumulation (g/L) |
| 100 (control) |
60.00 |
10.20 |
49.80 |
1,200 |
200 |
1,000 |
0.00 |
10.72 |
10.72 |
| 150 |
9.40 |
50.60 |
500 |
700 |
10.08 |
10.08 |
| 200 |
12.68 |
47.32 |
100 |
1,100 |
9.88 |
9.88 |
Download Excel Table
Fig. 7.
Effect of incubation temperature on the growth of Lactiplantibacillus plantarum CB5-30-3 in a 5 L jar fermenter. (A) Effect of optimal incubation temperature selection on optical density (OD600) measurements. (B) Effect of optimal incubation temperature selection on viable cell count (CFU/mL) measurements. Data are presented as mean±SD from three independent experiments (n=3).
Download Original Figure
Fig. 8.
Effect of pH on the growth of Lactiplantibacillus plantarum CB5-30-3 in a 5 L jar fermenter. (A) Effect of optimal pH selection on optical density (OD600) measurements. (B) Effect of optimal pH selection on viable cell count (CFU/mL) measurements. Data are presented as mean±SD from three independent experiments (n=3).
Download Original Figure
Fig. 9.
Effect of agitation speed on the growth of Lactiplantibacillus plantarum CB5-30-3 in a 5 L jar fermenter. (A) Effect of optimal agitation speed selection on optical density (OD600) measurements. (B) Effect of optimal agitation speed selection on viable cell count (CFU/mL) measurements. Data are presented as mean±SD from three independent experiments (n=3).
Download Original Figure
아래 결과에 언급될 탄소원 소비 효율과 젖산 축적량의 일반적 공정적 의미는 다음과 같다.
탄소원의 소비 속도와 잔존량은 균주 대사 효율과 공정 적합성을 평가하는 핵심 지표 중 하나이다. 탄소원이 일정 시간 내 효과적으로 소모되며 이에 상응하는 증가가 관찰될 경우, 이는 기질이 세포 성장 및 에너지 생산으로 효율적으로 전환되었음을 의미한다.
젖산 축적 패턴은 균주의 해당과정 활성 및 호모발효적 대사 특성을 반영하는 지표로 활용된다. 배양 후반부로 갈수록 젖산이 증가하는 것은 당 소비에 따른 정상적인 산 생성 경로를 의미하지만, 일정 농도 이상 축적될 경우 배양액의 pH를 급격히 낮추어 성장 속도 저하 또는 자기억제를 유발할 수 있다.
30℃ 조건에서는 높은 생균수를 유지하면서도 탄소원 소비 속도와 유기산 축적 속도가 가장 낮게 나타나, 에너지 효율성과 발효 안정성이 우수함을 시사하였다. 이 결과는 Xiao et al.의 보고와 유사하며, 이들은 28℃-32℃가 L. plantarum의 생육 및 기능성 유지에 적합한 온도 범위임을 제시하였다[16].
또한, pH 6.0에서 가장 높은 생균수가 관찰되었으며, 이는 Liao et al.이 제시한 pH 5.8–6.2의 최적 범위와 일치한다[17]. 교반 속도에서는 100 rpm이 가장 이상적인 조건으로 평가되었으며, 과도한 전단력은 생장 억제 요인으로 작용할 수 있음을 확인하였다. 이는 Loo et al.의 연구에서 언급된 바와 같이, 100–150 rpm이 L. plantarum 생장에 긍정적 영향을 주며, 그 이상에서는 세포 손상을 초래할 수 있다는 보고와도 일치한다[18].
결 론
본 연구에서는 김치로부터 분리한 다수의 유산균 중 안전성 평가와 분자생물학적·생화학적 동정을 거쳐 L. plantarum CB5-30-3 균주를 최종 선별하였다. 해당 균주는 용혈성, 젤라틴 분해, 바이오제닉 아민 생성 시험에서 모두 음성으로 판정되었고, 항생제 감수성 시험에서도 EFSA 기준을 충족하여 인체 적용의 안전성이 확보되었다. 더불어 다양한 탄수화물 대사 능력을 보유하여 기능적 활용 범위가 넓은 균주임을 확인하였다. 이는 김치 유래 L. plantarum 균주가 기능성과 안전성을 동시에 갖춘 산업적 자원으로서 가치가 높다는 점을 뒷받침한다.
생육 곡선 분석을 통해 stationary phase 진입 직전인 6시간을 최적 WCB 제작 시점으로 규명하였으며, 이는 균주의 대량 배양 시 고활성을 보장할 수 있는 전략적 지표가 된다. 배지 조성 연구 결과, soy peptone(A2SC), yeast extract(545MG), glucose의 조합이 최적 배양 소재로 확인되었으며, 특히 C:N 비 1:1.5에서 가장 우수한 성장 효율을 보였다. 이러한 결과는 L. plantarum JNU 2116에서 soy peptone–glucose–yeast extract 조합을 최적 배지로 보고한 Yoo et al.의 연구 및, L. plantarum Pi06 균주에서 glucose–yeast extract–soy peptone–corn steep liquor 조합을 활용하여 바이오매스를 증대시킨 Hwang et al.의 연구와 잘 부합한다[19,20]. 발효 공정 최적화 실험에서는 30℃, pH 6.0, 100 rpm 조건에서 가장 우수한 성장과 발효 효율을 나타냈다. 이는 L. plantarum 200655 균주를 대상으로 한 연구에서 30℃, pH 6.5, 200 rpm 조건에서 최대 생육이 보고된 Choi et al.과, L. plantarum AC11S 균주가 30℃, pH 6.5에서 가장 안정적인 젖산 생산성을 보였다고 한 Popova-Krumova et al.의 결과와 유사하다[21,22]. 또한, WCB 제작 시점을 stationary phase 직전으로 설정한 결과는 L. plantarum 200655 발효에서 6시간 이후 급격한 증식이 보고된 연구 결과와도 부합하며, 본 연구의 배양 전략이 실험실 규모뿐 아니라 대량 공정에서도 적용 가능한 타당성을 지님을 시사한다. 교반 속도의 경우, 본 연구는 100 rpm에서 최적 조건을 도출하였는데, 이는 균주 및 발효기 형태에 따라 150–200 rpm 범위에서 최적점이 보고된 선행 연구와 차이를 보인다[23]. 이러한 차이는 산소 전달, 발포 현상, 용기 형상 등 공정 특성에 따른 차별적 최적화 결과로 해석될 수 있으며, 본 연구에서 제시한 조건이 CB5-30-3 균주 특성에 특화된 최적점임을 보여준다.
결론적으로, 본 연구는 김치 유래 L. plantarum CB5-30-3 균주가 안전성, 생리적 다양성, 산업적 생산 효율성을 모두 충족하는 유망한 프로바이오틱 후보임을 실증적으로 확인하였다. 향후 연구에서는 본 균주의 장내 정착성, 면역 조절 효과, 대사산물 특성과 같은 기능성 검증, 그리고 스케일 업 발효 공정 확립이 필요할 것이다. 이를 통해 본 균주는 본 연구에서 확보한 균주의 발효 특성과 식물성 배지 적응성은 다양한 식물성 발효 제품 개발에 활용될 수 있다. 특히 귀리 기반의 plant-based 발효유 제품과 같은 대체 발효유에 적용하거나, 분말화 공정을 통해 비건용 기능성 프로바이오틱 파우더 제품으로 개발될 가능성이 있다. 이러한 응용 가능성은 본 균주가 식물성 기반 발효식품 및 프로바이오틱 분말 산업 전반에서 실질적인 산업적 활용 가치를 지님을 시사한다.